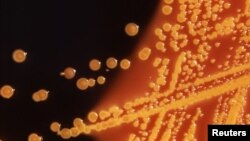

دانشمندانی که در جستجوی یافتن راههای جدید برای مبارزه با «ابرباکتریهای» مقاوم در برابر دارو هستند، ژنوم بیش از سه هزار باکتری از جمله موردی در بینی الکساندر فلمینگ و عامل اسهال خونی در بدن یک سرباز جنگ جهانی اول را شناسایی و ترسیم کردهاند.
پژوهشگران گفتند در این تحقیقات که با هدف شناخت بهتر برخی از خطرناکترین بیماریها و کشف راههای جدید برای مقابله با آنها انجام شده، «دیانای» برخی از بیماریهای مرگبار مثل اسهال خونی، طاعون و وبا نیز شناسایی شده است.
نمونه مربوط به الکساندر فلمینگ دانشمند بریتانیایی که در سال ۱۹۲۸ پنیسیلین را کشف کرد، از جمله بیش از پنج هزار و ۵۰۰ میکروب و باکتری است که در مرکز ملی شناخت باکتریها در بریتانیا جمعآوری شده است. این یکی از بزرگترین مراکز جمعآوری و تحقیقات در مورد باکتریهای بیماریزا در جهان است.
اولین مورد از باکتریهای بیماریزا که به این مرکز منتقل شد، عامل ابتلا به اسهال خونی است که در سال ۱۹۱۵ از یک سرباز در جبهههای جنگ جهانی اول گرفته شده است.
جولیان پارکهیل یکی از مسئولان این پژوهش گفت: «شناخت از وضعیت اولیه باکتریها قبل از شروع مصرف آنتیبیوتیک و مقایسه آن با مشخصات و نحوه عملکرد فعلی آنها به ما نشان میدهد که آنها در برابر درمانهای موجود چه واکنشی نشان دادهاند. این به ما کمک خواهد کرد تا آنتیبیوتیکها و واکسنهای جدیدی بسازیم».
ارزیابی متخصصان علوم پزشکی این است که حدود ۷۰ درصد از باکتریها حداقل در برابر آن نوع آنتی بیوتیکی که معمولا برای درمان آنها تجویز میشود، مقاوم شدهاند.
این روند به تکامل «ابر باکتریها» منجر شده که میتوانند از یک یا چند نوع دارو بگریزند و اکنون یکی از خطرهای بزرگی است که علم پزشکی با آن مواجه است.
یکی از جدیترین خطرها بیماری سل است که هر سال بیش از ۱۰ میلیون نفر در سراسر جهان به آن مبتلا میشوند و فقط در سال ۲۰۱۶ باعث مرگ ۱.۷ میلیون نفر شد.
بیماری مقاربتی سوزاک نیز یکی دیگر از این موارد است که هر سال ۷۸ میلیون نفر به آن مبتلا میشوند و سازمان بهداشت جهانی میگوید تقریبا دارد به یکی از بیماریها لاعلاج تبدیل میشود.
نتایج این پژوهش در مورد ژنوم بیش از سه هزار باکتری قرار است در سایت «مرکز ملی شناخت باکتریها» در بریتانیا منتشر شود و آزادانه در اختیار پژوهشگران در سراسر جهان قرار خواهد گرفت تا از این اطلاعات برای پیدا کردن راههای جدید معاینه و معالجه و تولید دارو و واکسن استفاده کنند.